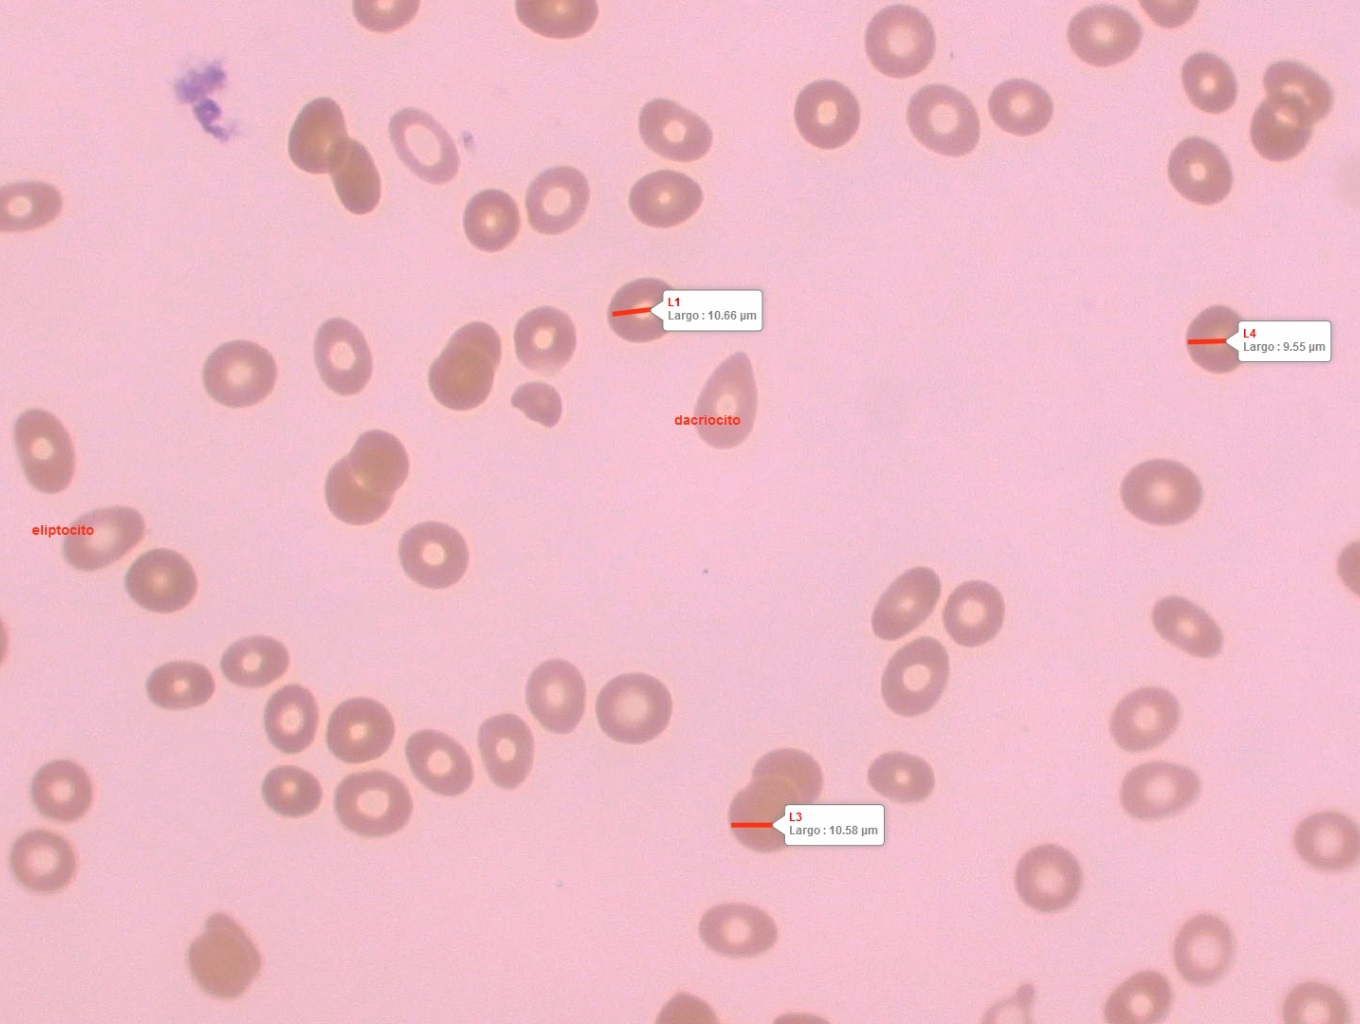

Conscientes de la necesidad de acudir en ayuda de nuestros pacientes del Consultorio Asociado de Especialidades del Hospital de Quilpué (CAE) que se encuentran postrados, a partir del día jueves 13 de octubre personal de toma de muestras de laboratorio acudirá al domicilio de quienes lo requieran. El único requisito es inscribir al paciente...
Noticias
Desde septiembre de 2022 un equipo multidisciplinario formado por profesionales tecnólogos médicos, bioquímico y técnico nivel superior de laboratorio entregan apoyo a la unidad de categorización de la unidad de emergencias adulto del Hospital de Quilpué. Con el trabajo cumplido durante un mes, se ha logrado reducir los tiempos de atención de los...
Nuevo equipo Vitros 7600 sin consumo de agua
Laboratorio Clínico Hospital de Quilpué licitó un equipamiento para el análisis automatizado de Química, Hormonas y Marcadores Tumorales Vitros 7600, único en la región, con capacidad para el proceso de 1200 test/hora, sin consumo de agua (amigable con el medio ambiente) y disponible para todos los pacientes del Hospital de Quilpué. El equipo...
El día 25 de noviembre recién pasado, Laboratorio Clínico Hospital de Quilpué festejó a sus TENS, reconociendo su excelente labor y muy especialmente durante la Pandemia Covid-19. Los integrantes del equipo entregaron un presente a todas las funcionarias y las agasajaron como se merecen.
Gracias a un esfuerzo conjunto entre la unidad de Hematología del Hospital de Quilpué, coordinada por la T.M. Srta. Oriana Contreras Becker, y la Empresa Valtek Diagnostics se ha instalado recientemente un microscopio óptico y cámara Motic, unidos a un software Motic Images Plus 3.0 que permite entregar imágenes y videos de hemogramas sanguíneos...
Nuestro Laboratorio tiene el orgullo de celebrar los 25 años de Servicio Público de nuestra Químico Farmacéutica María Paz Gándara Balbontín (En video minuto 3:08).
Durante el presente mes de septiembre, Laboratorio Hospital Quilpué ha asistido junto al equipo de Hospitalización Domiciliaria para apoyar en el diagnóstico de los pacientes que requieren exámenes de laboratorio urgentes. Esto es parte de un Plan Piloto que permitirá dilucidar la utilidad práctica del equipo de Laboratorio en los domicilios, la...
Laboratorio de Química Clínica
En Química Clínica nuestro Laboratorio dispone de equipamiento de última generación y procesa con equipos de Química Seca que no ocupan agua y no se generan desechos líquidos. Los slide (especie de estampilla) contienen los reactivos en fase sólida que al ponerse en contacto con la muestra de sangre generan una reacción luminiscente que es...
Nuevo Coagulómetro CS 2100 i
Un equipo que se encuentra en etapa de validación y análisis en nuestro Laboratorio. Permite medir exámenes de coagulación con máxima rapidez. Dentro de su amplio menú, puede efectuar análisis de trombofilia desde el Factor I, Protrombina, TTPK, Anticoagulante Lúpico, Dímero D, Proteína C, Proteína S y Antitrombina III. Es un aporte para evaluar...
Microscopía Inmunofluorescencia Indirecta
Laboratorio Clínico Hospital de Quilpué cuenta con un microscopio de inmunofluorescencia indirecta para procesar numerosas muestras con técnicas complementarias a los Test de Screening Elisa y permite resultados confirmatorios con patrones específicos semi cuantitativos.